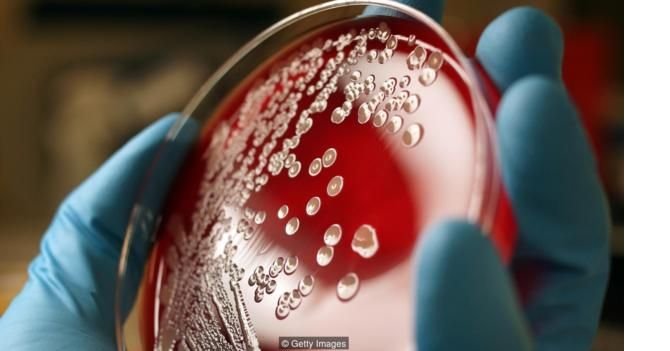

Mikropların yayılmasını önlemenin en iyi yolunun el yıkamaktan geçtiğini herkes bilir. Birçok yerde gıda sektöründe çalışanların ellerini temiz tutması için kamu sağlığı yasaları çıkarılır. Fakat öte yandan eller ne kadar iyi yıkanırsa yıkansın bakteriden tümüyle temizlemenin yolu yoktur.
Elleri steril yapmanın yolu olmadığı için doktorlar ve hemşireler hastalarla ilgilenirken eldiven takar. Yüz yıl kadar önce doktorlar ellerini defalarca yıkasalar da testlerde hala bakteri çıktığını tespit ettiler. Ama bu bakterilerin neden bu kadar dirençli olduğu 1970’lere kadar bulunamamıştı.
Parmak uçlarını kaplamanın elleri daha uzun süre temiz tuttuğu fark edildi. Fakat aslında kirli olan parmak uçları değil de tırnaklardır. Keratinden oluşan tırnaklar çok sayıda bakteriye yuva olur.
Yüzbinlerce bakteri
1980’lerde bilim insanları tırnakların ne tür canlılar barındırdığını incelemeye başladı. 1988’de Pensilvanya Üniversitesi Dermatoloji Bölümü’nden araştırmacılar, üniversitenin tıp fakültesinden, hastalarla yüz yüze olmayan 26 çalışanın tırnaklarından örnek aldı.
Özellikle tırnak içlerinin çok sayıda bakteri barındırdığı görüldü. Deneklerin ellerinin diğer kısımlarında binlerce bakteri varken her tırnak içinde yüz binlercesi vardı. Burada da elin diğer kısımlarıyla aynı bakteriler bulunuyor, ama çok daha fazla sayıda olduğu görülüyordu.
Araştırmacılar tırnak içlerinin mikropların barınması için uygun nem ve koruyucu ortamı sağladığına inanıyor. Ovuşturulup fırçalanarak yıkanması halinde bile ellerin tümüyle sterilize olmadığı daha önce biliniyordu. Bu araştırmada da mikrop öldürücü sabunun tırnakların arasına yeterince nüfuz edip tüm mikropları öldürmediği sonucuna varıldı.
Başka bir araştırma da hemşirelerin tırnak içlerinde barınan mikropları araştırıyor. Burada hem doğal, hem de takma tırnaklara ve ojeli tırnaklara tek tek bakılıyor.
Takma tırnaklar
1989’da bir grup hemşire şunları söylüyordu: “Takma tırnakların güvenli ve pratik olup olmadığına dair cevapsız sorular olsa da birçok sağlık çalışanı takma tırnak modasına uymaya başladı.”
Doğal tırnaktan daha uzun ve sürekli ojeli takma tırnak takan 56 hemşirenin tırnak içlerindeki bakteri sayısının doğal tırnaklı 56 hemşireninkinden daha fazla olup olmadığına bakıldı. Ayrıca el yıkamanın takma tırnaklılarda ne kadar etkili olduğu incelendi.
Yıkama öncesi ve sonrasında takma tırnaklı hemşirelerin tırnak içlerinde daha fazla bakteri olduğu görüldü. Bu onların hastalara daha fazla bakteri bulaştırdığı anlamına gelmiyor, sadece parmak uçlarında daha fazla sayıda bakteri olduğunu ortaya koyuyordu. Fakat daha fazla bakteri olması en azından bunların bulaşma potansiyelini artırdığı anlamına gelebilirdi.
2000 ve 2002 yıllarında yayımlanan benzer araştırmalar da benzer sonuçlar vermişti. Takma tırnaklı hemşirelerde düzgün el yıkamama ve eldivenlerin yırtılması sorunu yaşanıyordu.
Oje etkisi
Ojeli doğal tırnaklar ise başka bir soruna kapı aralıyor. Ojenin çatlaması ve kısmen çıkması halinde bu aralıklara daha fazla bakteri toplanır. 1993’te Baltimore’daki John Hopkins Hastanesinde doğrudan hastalarla çalışmayan 26 kadın çalışanın tırnakları incelendi. Tümü kısa tırnaklıydı ve hem ojesizken hem de oje sürdükten dört gün sonra tırnaklara bakıldı.
Doğal tırnaklardaki ojelerin parmak ucu mikrop çeşidi bakımından takma tırnaktaki kadar etkili olmadığı görüldü. Yani tırnakta oje olup olmamasından çok onları kısa ve temiz tutmak daha önemliydi. Başka bir araştırmada ise dört günlük ojeli tırnakların yeni ojeli tırnaklara kıyasla daha fazla bakteri barındırdığı görüldü.
Her yıl iki-üç milyon kadar insanın ishalden öldüğü biliniyor. Elleri sabunla yıkamanın bir milyon insanı kurtaracağı tahmin ediliyor. Fakat eldeki bakteri sayısını azaltmanın yolu tırnak aralarına özen göstererek elleri yıkamaktan, tırnakları kısa ve temiz tutmaktan geçiyor.





















-001.gif)





































Türkçe karakter kullanılmayan ve büyük harflerle yazılmış yorumlar onaylanmamaktadır.